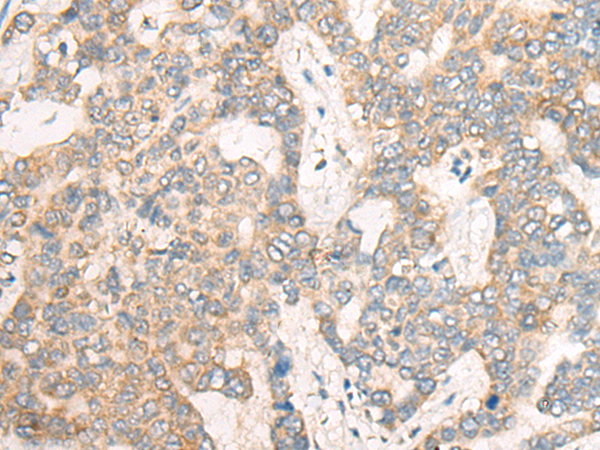

中文名稱: 兔抗CSNK1G1多克隆抗體
|
Background: |
This gene encodes a member of the casein kinase I gene family. This family is comprised of serine/threonine kinases that phosphorylate acidic proteins such as caseins. The encoded kinase plays a role in cell cycle checkpoint arrest in response to stalled replication forks by phosphorylating Claspin. A mutation in this gene may be associated with non-syndromic early-onset epilepsy (NSEOE). |
|
Applications: |
ELISA, IHC |
|
Name of antibody: |
CSNK1G1 |
|
Immunogen: |
Synthetic peptide of human CSNK1G1 |
|
Full name: |
casein kinase 1 gamma 1 |
|
Synonyms: |
CK1gamma1 |
|
SwissProt: |
Q9HCP0 |
|
ELISA Recommended dilution: |
5000-10000 |
|
IHC positive control: |
Human liver cancer; |
|
IHC Recommend dilution: |
25-100 |
購物車
購物車 幫助
幫助
 021-54845833/15800441009
021-54845833/15800441009
